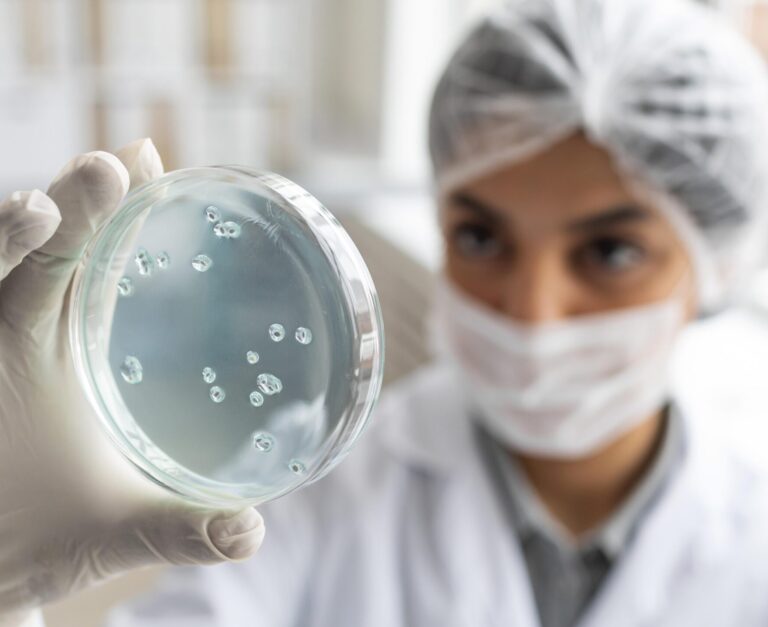

Gewijzigde LCI-producten oktober 2025
04 nov '25
18
nov '25
Consulent openbare medische microbiologie (COM), 8 uur per week – RIVM, Bilthoven
Reageren voor: 10 nov '25
Uitnodiging deelname werkgroep voor richtlijn Prionziekten – medisch specialistische zorg
Reageren voor: 10 nov '25
Arts-microbioloog – Erasmus MC – Rotterdam
Reageren voor: 15 nov '25
Vacature arts-microbioloog (0,5-1,0 Fte) – Veldhoven
Reageren voor: 29 nov '25
Medisch Moleculair Microbioloog – Isala Zwolle
Reageren voor: 01 dec '25
Voor vacatures van de NVMM dient u eerst hier in te loggen.

Pandemische paraatheid
Pandemische paraatheid
In de eerste aflevering van het nieuwe seizoen van MedMic interviewen we prof. dr. Marion Koopmans, hoogleraar virologie in het Erasmus MC. Marion vertelt ons over haar plannen na het pensioen, waarbij ze vooral extra aandacht heeft voor pandemic preparedness.